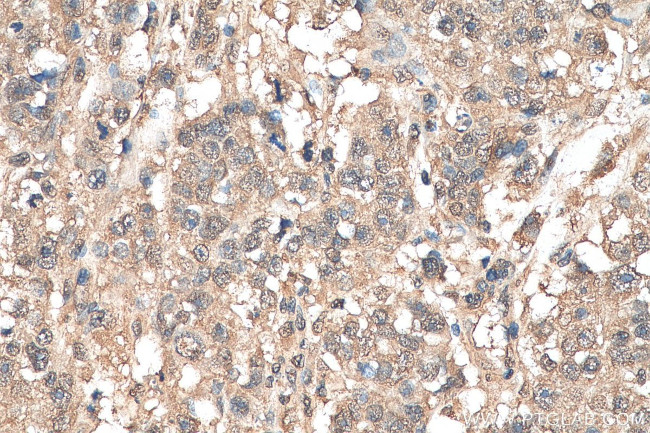
ETV6 Antibody in Immunohistochemistry (Paraffin) (IHC (P))

Search
Proteintech
ETV6 Monoclonal Antibody (2A5A2)
{{$productOrderCtrl.translations['antibody.pdp.commerceCard.promotion.promotions']}}
{{$productOrderCtrl.translations['antibody.pdp.commerceCard.promotion.viewpromo']}}
{{$productOrderCtrl.translations['antibody.pdp.commerceCard.promotion.promocode']}}: {{promo.promoCode}} {{promo.promoTitle}} {{promo.promoDescription}}. {{$productOrderCtrl.translations['antibody.pdp.commerceCard.promotion.learnmore']}}
产品信息
67579-1-IG150UL
种属反应
宿主/亚型
分类
类型
克隆号
偶联物
形式
浓度
纯化类型
保存液
内含物
保存条件
运输条件
靶标信息
This gene encodes an ETS family transcription factor. The product of this gene contains two functional domains: a N-terminal pointed (PNT) domain that is involved in the protein-protein interactions with itself and other proteins, and a C-terminal DNA-binding domain. Gene knockout studies in mice suggest that it is required for hematopoiesis and Maintenance of the developing vascular network. This gene is known to be involved in a large number of chromosomal rearrangements associated with leukemia and congenital fibrosarcoma.
仅用于科研。不用于诊断过程。未经明确授权不得转售。
篇参考文献 (0)
生物信息学
蛋白别名: CGI-108; CSL4; Csl4p; ETS translocation variant 6; ets variant gene 6 (TEL oncogene); ETS-related protein Tel1; hCsl4p; p13; RP11-452K12.9; SKI4; Ski4p; Tel; TEL1 oncogene; Transcription factor ETV6
基因别名: ETV6; TEL; TEL/ABL; TEL1; THC5
UniProt ID: (Human) P41212
Entrez Gene ID: (Human) 2120